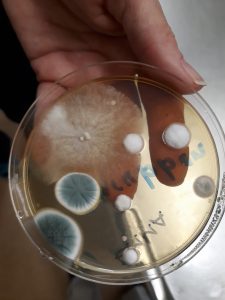
hitta mögel

Dieter… i mängd och trängsel
Dieter… i mängd och trängsel
En diet som är bra för mig behöver inte alls vara det för dig. Det vore tvärtom konstigt om det vore så eftersom vi är olika. Det går mode i dieter, och jag upplever den unga generationen som regelrätt lurade. De är uppväxta i lightproduktsamhället, och idag vet vi att sockerbolagen öste ut miljon efter miljon för att varna för ”fett”…
Jag minns då alla skulle äta fem brödskivorom dagen…
Vem som betalade varningarna för ägg har jag inte koll på. Jag gick aldrig på ägg-larmen eftersom jag i min barndom hade umgåtts med 90-åringar som ätit ägg hela livet. Dieterna skulle aldrig få fotfäste om folk började tänka i funktion.
– Vad gör just denna råvara med min kropp?

Många i skolan vet numera vad gurkmeja, kardemumma, kokosmjölk och vaniljestrakt, mer mera, gör och känslan av att man plötsligt kan räkna igen glömmer man aldrig.
Det sägs att folk minns vad de gjorde då statsminister Palme sköts. Jag vill påstå att man minns, på samma sätt, livet ut den dag man fick sitt närminne tillbaka.
 Speciellt om man, som jag, konstant betalade räkningar tre gånger eller inte alls, och vände på precis alla siffror man kan vända på.
Speciellt om man, som jag, konstant betalade räkningar tre gånger eller inte alls, och vände på precis alla siffror man kan vända på.
Idag vet skolans medlemmar att Guldmjölkens funktion är att slå ner inflammationen. Den som tänker i funktion behöver inga dieter. Men det är ingalunda enbart guldmjölken som har den funktionen. UMS-programmet är noga igenomtänkt, och läkarkontrollerat.
Den som har koll på läget vet att skolan är ett handlingsprogram ut ur mörkret, och vi får se inom sex månader hur många det är som tar sig ut.
En sak vet jag; de har gått in för matens funktion, och inte dieter
De känner också väl till att de kilon vi drar på oss hänger samman med hormoner och förgiftningar. Kan man inte äta eller ens springa bort.
UMS tar aldrig bort, UMS lägger till och en av de saker vi lägger till är blåbär, som är rena hjärnmaten. Allt det vi lägger till är i allmänhet ren hjärnmat. Funktionsmat, som blåbär.
Här har v i en läkare som går matvägen
11 trendiga dieter – så effektiva är de
Periodisk fasta, LCHF, Ketos, Atkins, VLCD, GI, Paleo och så vidare.
Idag finns en mängd trendiga dieter som kan vara svåra att skilja åt.
Här ger vi en generell översikt av några av dieterna.
Överlag brukar vi på Wellobe säga att det viktiga är att hitta en diet som fungerar för dig. För alla är vi olika med olika bakgrunder, genetik, förutsättningar, levnadsvanor, preferenser, målsättningar – och så vidare. Samtidigt kan olika dieter vara olika bra rent hälsomässigt. Vissa kan till och med vara farliga och därför är det viktigt att man verkligen förstår vad det är man utsätter sig själv och sin kropp för.
Diet 1: Periodisk fasta
Periodisk fasta (intermittent fasting) är ett samlingsnamn på dieter som går ut på att växla mellan att äta ”som vanligt” och att fasta. Här är några vanliga varianter:
- 5:2-dieten: Ät som vanligt fem dagar (ca 2 000–2 500 kcal/dag) och fasta i två (ca 500–600 kcal/dag).
- 6:1-dieten: Ät som vanligt sex dagar och drick bara livsmedel utan kalorier dag sju.
- 16:8-dieten: Fasta i 16 timmar och ät i 8.
- 20:4-dieten: Fasta i 20 timmar och ät i 4.
Vad man ska äta enligt denna diet
Det väljer man själv, så länge man håller sig inom sin rekommenderade kalorinivå. Bra val är näringsrika livsmedel med mycket protein och fiber som mättar utan att tillföra för mycket kalorier. Även soppor har i studier visat sig ge mättnadskänslor.
Skulle t ex 5:2-dieten passa dig? TESTA HÄR
För- och nackdelar med denna diet
Fördelar
Att man minskar sitt totala kaloriintag samtidigt som man kan äta vad man vill. Det leder oftast till att man går ner i vikt. Studier visar att dieten både minskar mängden hungerhormon (ghrelin) och ökar mängden mättnadshormon (leptin). Dessutom sägs den stimulera tillväxthormon som förebygger muskelnedbrytning.
Nackdelar
Att vara utan mat länge passar inte alla. Risken är att man överkompenserar efteråt, så har man haft ätstörningar är denna diet inte att rekommendera. Generellt sett är hälsoeffekterna dessutom kortsiktiga och vare sig fler eller bättre i jämförelse med dieter där man minskar kaloriintaget lika mycket varje dag. En annan risk är att man går upp lika snabbt i vikt igen – om inte mer – när man väl slutar.
Diet 2: LCHF
LCHF (Low Carb High Fat el. ”lågkolhydratkost”) är en diet som går ut på att minska mängden kolhydrater och öka mängden fett. Är godkänd av Socialstyrelsen som behandling av övervikt och diabetes typ 2. Kallas av sina förespråkare för ”njutmetoden” eftersom man får frossa i kött och såser baserade på feta mejeriprodukter som grädde, smör och créme fraiche.
Men hur går det ihop? Jo, i vanliga fall är kroppens främsta energikälla kolhydrater som bryts ner till glukos och sedan blodsocker. Syftet med den här dieten är att tvinga kroppen att istället inhämta sin energi från fett, genom att minska på kolhydraterna (läs mer om ”ketos” under Diet 3 nedan).
Vad man ska äta enligt denna diet
- Kött, fågel, fisk, skaldjur och ägg
- Feta mejeriprodukter som smör, ost, grädde och creme fraiche
- ”Ovan-jord-grönsaker”
- Bär
- Nötter (OBS! Ej nötter med kolhydrater)
Vad man INTE ska äta enligt denna diet
- Bröd, ris, pasta och potatis
- Socker och annan stärkelserik mat
- Frukt
- Chips
- Vin, öl och drinkar
För- och nackdelar med denna diet
Fördelar
Passar bra för människor som tycker om kött och och fet mat. Dessutom bidrar fettet till en ökad mättnad, så att man inte blir hungrig lika ofta. Eftersom man också undviker socker minskar sötsuget med tiden.
Nackdelar
Att den innehåller så mycket fett. Det sägs både öka fettinlagringen på insidan runt organen samt kolesterolhalten, vilket i sin tur ökar risken för hjärt- kärlsjukdom. Dessutom är avsaknaden av glukos en negativ aspekt, då glukos är hjärnans bränsle. Livsmedelsverket rekommenderar inte att man slutar äta kolhydrater helt, utan anser istället att man byter ut snabba kolhydrater som vitt ris, pasta och potatis mot fullkornsprodukter.

Hitta mögel, på liv eller död
Hitta mögel, på liv eller död


 [ez-toc]
[ez-toc] Om det hade varit ”stress” hade jag förmodligen blivit ännu sjukare, än vad jag redan var, bara av F-kassans hantering.
Om det hade varit ”stress” hade jag förmodligen blivit ännu sjukare, än vad jag redan var, bara av F-kassans hantering. Vi avgiftar brett och bygger immunförsvar, och vi använder oss av labb i Tyskland och USA och i kurs 3 kan man koppla upp sig mot läkarna på ett sjukhus i Indien och få individuell hjälp och de som kan / har råd kan även åka ner.
Vi avgiftar brett och bygger immunförsvar, och vi använder oss av labb i Tyskland och USA och i kurs 3 kan man koppla upp sig mot läkarna på ett sjukhus i Indien och få individuell hjälp och de som kan / har råd kan även åka ner. Nej, det har mycket mer med gifter att göra än ålder, och det ser vi på medlemmens före och efterbild. Hon har fått tillbaka sin hårfärg, det glänser om håret, samt att ”leverrynkan”, två hack mellan ögonen, har börjat ge med sig liksom den svullnad som alltid finns i botten.
Nej, det har mycket mer med gifter att göra än ålder, och det ser vi på medlemmens före och efterbild. Hon har fått tillbaka sin hårfärg, det glänser om håret, samt att ”leverrynkan”, två hack mellan ögonen, har börjat ge med sig liksom den svullnad som alltid finns i botten. Hela skolans utbildning kommer jag att säkra bokvägen, eftersom vi vet att UMS-metoden fungerar, och jag räknar med att ha allt mellan bokpärmar år 2025.
Hela skolans utbildning kommer jag att säkra bokvägen, eftersom vi vet att UMS-metoden fungerar, och jag räknar med att ha allt mellan bokpärmar år 2025. Jag har börjat låta översätta en del av materialet till engelska därför att det är min erfarenhet att omvärlden kan ibland sätta press på Sverige, som gärna vill vara den humanitära stormakten.
Jag har börjat låta översätta en del av materialet till engelska därför att det är min erfarenhet att omvärlden kan ibland sätta press på Sverige, som gärna vill vara den humanitära stormakten.

 Det var nåt mediaorgan som hade undersökt ”tumeric”, och fann den verkningslös, och det är väl inte helt otroligt att de använt kapslar eller steriliserad och död gurkmeja.
Det var nåt mediaorgan som hade undersökt ”tumeric”, och fann den verkningslös, och det är väl inte helt otroligt att de använt kapslar eller steriliserad och död gurkmeja. En medlem ville ha ”alla” att byta ut John Lemon mot en påse askorbinsyra, och man kan byta ut skolans alla livsmedel mot spik om man så önskar – men aldrig utan konsekvenser.
En medlem ville ha ”alla” att byta ut John Lemon mot en påse askorbinsyra, och man kan byta ut skolans alla livsmedel mot spik om man så önskar – men aldrig utan konsekvenser. Jag öppnade en FB-grupp och vi var snabbt flera hundra, och skälet till intresset berodde på att jag själv hade varit sjuk men återhämtat mig helt i Asien. De ville veta hur…
Jag öppnade en FB-grupp och vi var snabbt flera hundra, och skälet till intresset berodde på att jag själv hade varit sjuk men återhämtat mig helt i Asien. De ville veta hur… Jag skrev
Jag skrev 
 Man tror att det är cirka 300 000 drabbade i Sverige, och 3 miljoner i hela Europa, så UMS kommer att bli flerspråkigt på sikt.
Man tror att det är cirka 300 000 drabbade i Sverige, och 3 miljoner i hela Europa, så UMS kommer att bli flerspråkigt på sikt.

 IBS, och läckande tarm, är ett annat symtom som vi kommer in på. Många läkare ute i världen anser att inflammationsroten sitter i tarmen, och det ska vi studera ingående.
IBS, och läckande tarm, är ett annat symtom som vi kommer in på. Många läkare ute i världen anser att inflammationsroten sitter i tarmen, och det ska vi studera ingående. Medborgare i väst gör kanske stora ögon om man säger att en botten på sjukdomen är undernäring men västs läkare vet redan att det blir nästa stora medicinska hypade grej.
Medborgare i väst gör kanske stora ögon om man säger att en botten på sjukdomen är undernäring men västs läkare vet redan att det blir nästa stora medicinska hypade grej. Jag är helt botad utomlands, och då jag förstod hur man ”vårdar” oss i Sverige, och läste att
Jag är helt botad utomlands, och då jag förstod hur man ”vårdar” oss i Sverige, och läste att  Jag levde, som de flesta svenskar, ett helt odrägligt liv, med enorma mängder materia, som måste skötas runt mig.
Jag levde, som de flesta svenskar, ett helt odrägligt liv, med enorma mängder materia, som måste skötas runt mig.



 I början av 2000-talet larmades det om problemet, och AB påstod att en miljon var mögelsjuka, och sen försvann frågan, och vi fick istället floder med artiklar med rubriker av typen ”den psykiska ohälsan ökar”.
I början av 2000-talet larmades det om problemet, och AB påstod att en miljon var mögelsjuka, och sen försvann frågan, och vi fick istället floder med artiklar med rubriker av typen ”den psykiska ohälsan ökar”.
 Minskad förmåga att koncentrera dig (hjärndimma), depression, magont, värk, personlighetsförändringar, humörsvängningar, ökad ångest och panikreaktioner , letargi och apati, aggression, nedsatt närminne, (hjärndimma), oro, blödande tandkött, blödningar i hjärnan, blödningstendens, blod som inte koagulerar, dimsyn och synrubbningar, benmärgsstörningar, brännande känsla i munnen, bröstsmärta, kronisk trötthet, återkommande infektioner och influensakänslor, minskade sensorisk skärpa, koma, förvirring, hosta, krypningar i huden, skador på hjärtat, diarré, andningssvårigheter, koncentrationssvårigheter, ökad tendens till alkohol, socker och cigarettberoende , långsammare reflexer och svårare att tala, desorientering, yrsel, dåsighet, ögonskador, ögoninflammation, feber, håravfall, hallucinationer, huvudvärk, hörselnedsättning, inflammation i hjärtat, inre blödningar, nedsatt immunförsvar, oregelbundna hjärtslag, kliande näsa, gulsot, ledvärk, stelhet i leder, minskad sexlust, leversjukdomar, lågt blodtryck, minnesförlust och minnesproblem, muskelsmärta, illamående, näsblod, domningar, lungödem, röda ögon, rinnande näsa, anfall, skakningar, försämrade reflexer, halsont, stickningar, darrningar, kräkningar, kräkas blod, svaghet, viktminskning, väsande andning och stressat beteende.
Minskad förmåga att koncentrera dig (hjärndimma), depression, magont, värk, personlighetsförändringar, humörsvängningar, ökad ångest och panikreaktioner , letargi och apati, aggression, nedsatt närminne, (hjärndimma), oro, blödande tandkött, blödningar i hjärnan, blödningstendens, blod som inte koagulerar, dimsyn och synrubbningar, benmärgsstörningar, brännande känsla i munnen, bröstsmärta, kronisk trötthet, återkommande infektioner och influensakänslor, minskade sensorisk skärpa, koma, förvirring, hosta, krypningar i huden, skador på hjärtat, diarré, andningssvårigheter, koncentrationssvårigheter, ökad tendens till alkohol, socker och cigarettberoende , långsammare reflexer och svårare att tala, desorientering, yrsel, dåsighet, ögonskador, ögoninflammation, feber, håravfall, hallucinationer, huvudvärk, hörselnedsättning, inflammation i hjärtat, inre blödningar, nedsatt immunförsvar, oregelbundna hjärtslag, kliande näsa, gulsot, ledvärk, stelhet i leder, minskad sexlust, leversjukdomar, lågt blodtryck, minnesförlust och minnesproblem, muskelsmärta, illamående, näsblod, domningar, lungödem, röda ögon, rinnande näsa, anfall, skakningar, försämrade reflexer, halsont, stickningar, darrningar, kräkningar, kräkas blod, svaghet, viktminskning, väsande andning och stressat beteende.

 Vi har därför
Vi har därför 
 Jag är i botten författare, och skriver vad jag vill, och det blir givetvis som natt och dag.
Jag är i botten författare, och skriver vad jag vill, och det blir givetvis som natt och dag.
